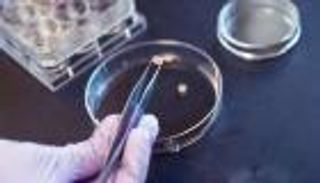
غضروف مُصمم هندسيا لعلاج هشاشة العظام

علاج المستقبل.. غضروف ذكي يوقف التهاب المفاصل عند بدايته

طور باحثون بجامعة كامبريدج "غضروفاً ذكياً" يطلق العلاج مباشرة عند بداية نوبة التهاب المفاصل.
والعلاج عبارة عن مادة مرنة تحاكي الغضروف قادرة على استشعار التغيرات الطفيفة داخل الجسم، مثل بداية نوبة التهاب المفاصل، وتطلق الأدوية المضادة للالتهاب تماماً في المكان والوقت المناسبين.

ويمكن تحميل تلك المادة بالأدوية، وتستجيب للتغيرات الطبيعية في درجة الحموضة (pH) داخل المفصل الملتهب. فعند بداية النوبة، يصبح المفصل أكثر حموضة قليلاً، ما يجعل المادة أكثر ليونة وتشبه الجيلي، لتطلق حينها جزيئات الدواء المخزنة بداخلها.
وقال البروفيسور أورين شيرمان، من قسم الكيمياء في جامعة كامبريدج، ومطور المادة: "لطالما اهتممنا باستخدام هذه المواد في المفاصل، حيث يمكنها محاكاة خصائص الغضروف، ولكن الجمع بين ذلك وإطلاق الدواء المستهدف يمثل خطوة مثيرة للغاية".
وأوضح الدكتور ستيفن أونيل، المؤلف الرئيسي للدراسة، أن المادة تستطيع "استشعار حدوث المشكلة في الجسم والاستجابة بتوصيل العلاج مباشرة إلى المكان الذي يحتاجه"، مما يقلل الحاجة إلى جرعات متكررة ويحسن جودة حياة المرضى.
وتمتاز هذه التقنية بأنها تستفيد من كيمياء الجسم نفسها، دون الحاجة لمحفزات خارجية مثل الحرارة أو الضوء. وتشير التجارب المخبرية إلى أن المادة تطلق كمية أكبر من الدواء عند درجة الحموضة الخاصة بالمفاصل الملتهبة مقارنة بالمستويات الطبيعية، ما يعزز من فعالية العلاج ويقلل الأعراض الجانبية.

وأكد الباحثون أن المادة يمكن تكييفها لعلاج أمراض أخرى مثل السرطان، ومن المتوقع أن تفتح هذه التقنية المجال لجيل جديد من المواد الحيوية الذكية التي تستجيب تلقائياً للنوبات المرضية، مما يزيد من دقة العلاج واستمراريته.
الدراسة نشرت في مجلة الجمعية الكيميائية الأمريكية، ويخطط الفريق للمرحلة التالية لاختبار المادة في أنظمة حية لتقييم فعاليتها وسلامتها في الجسم.